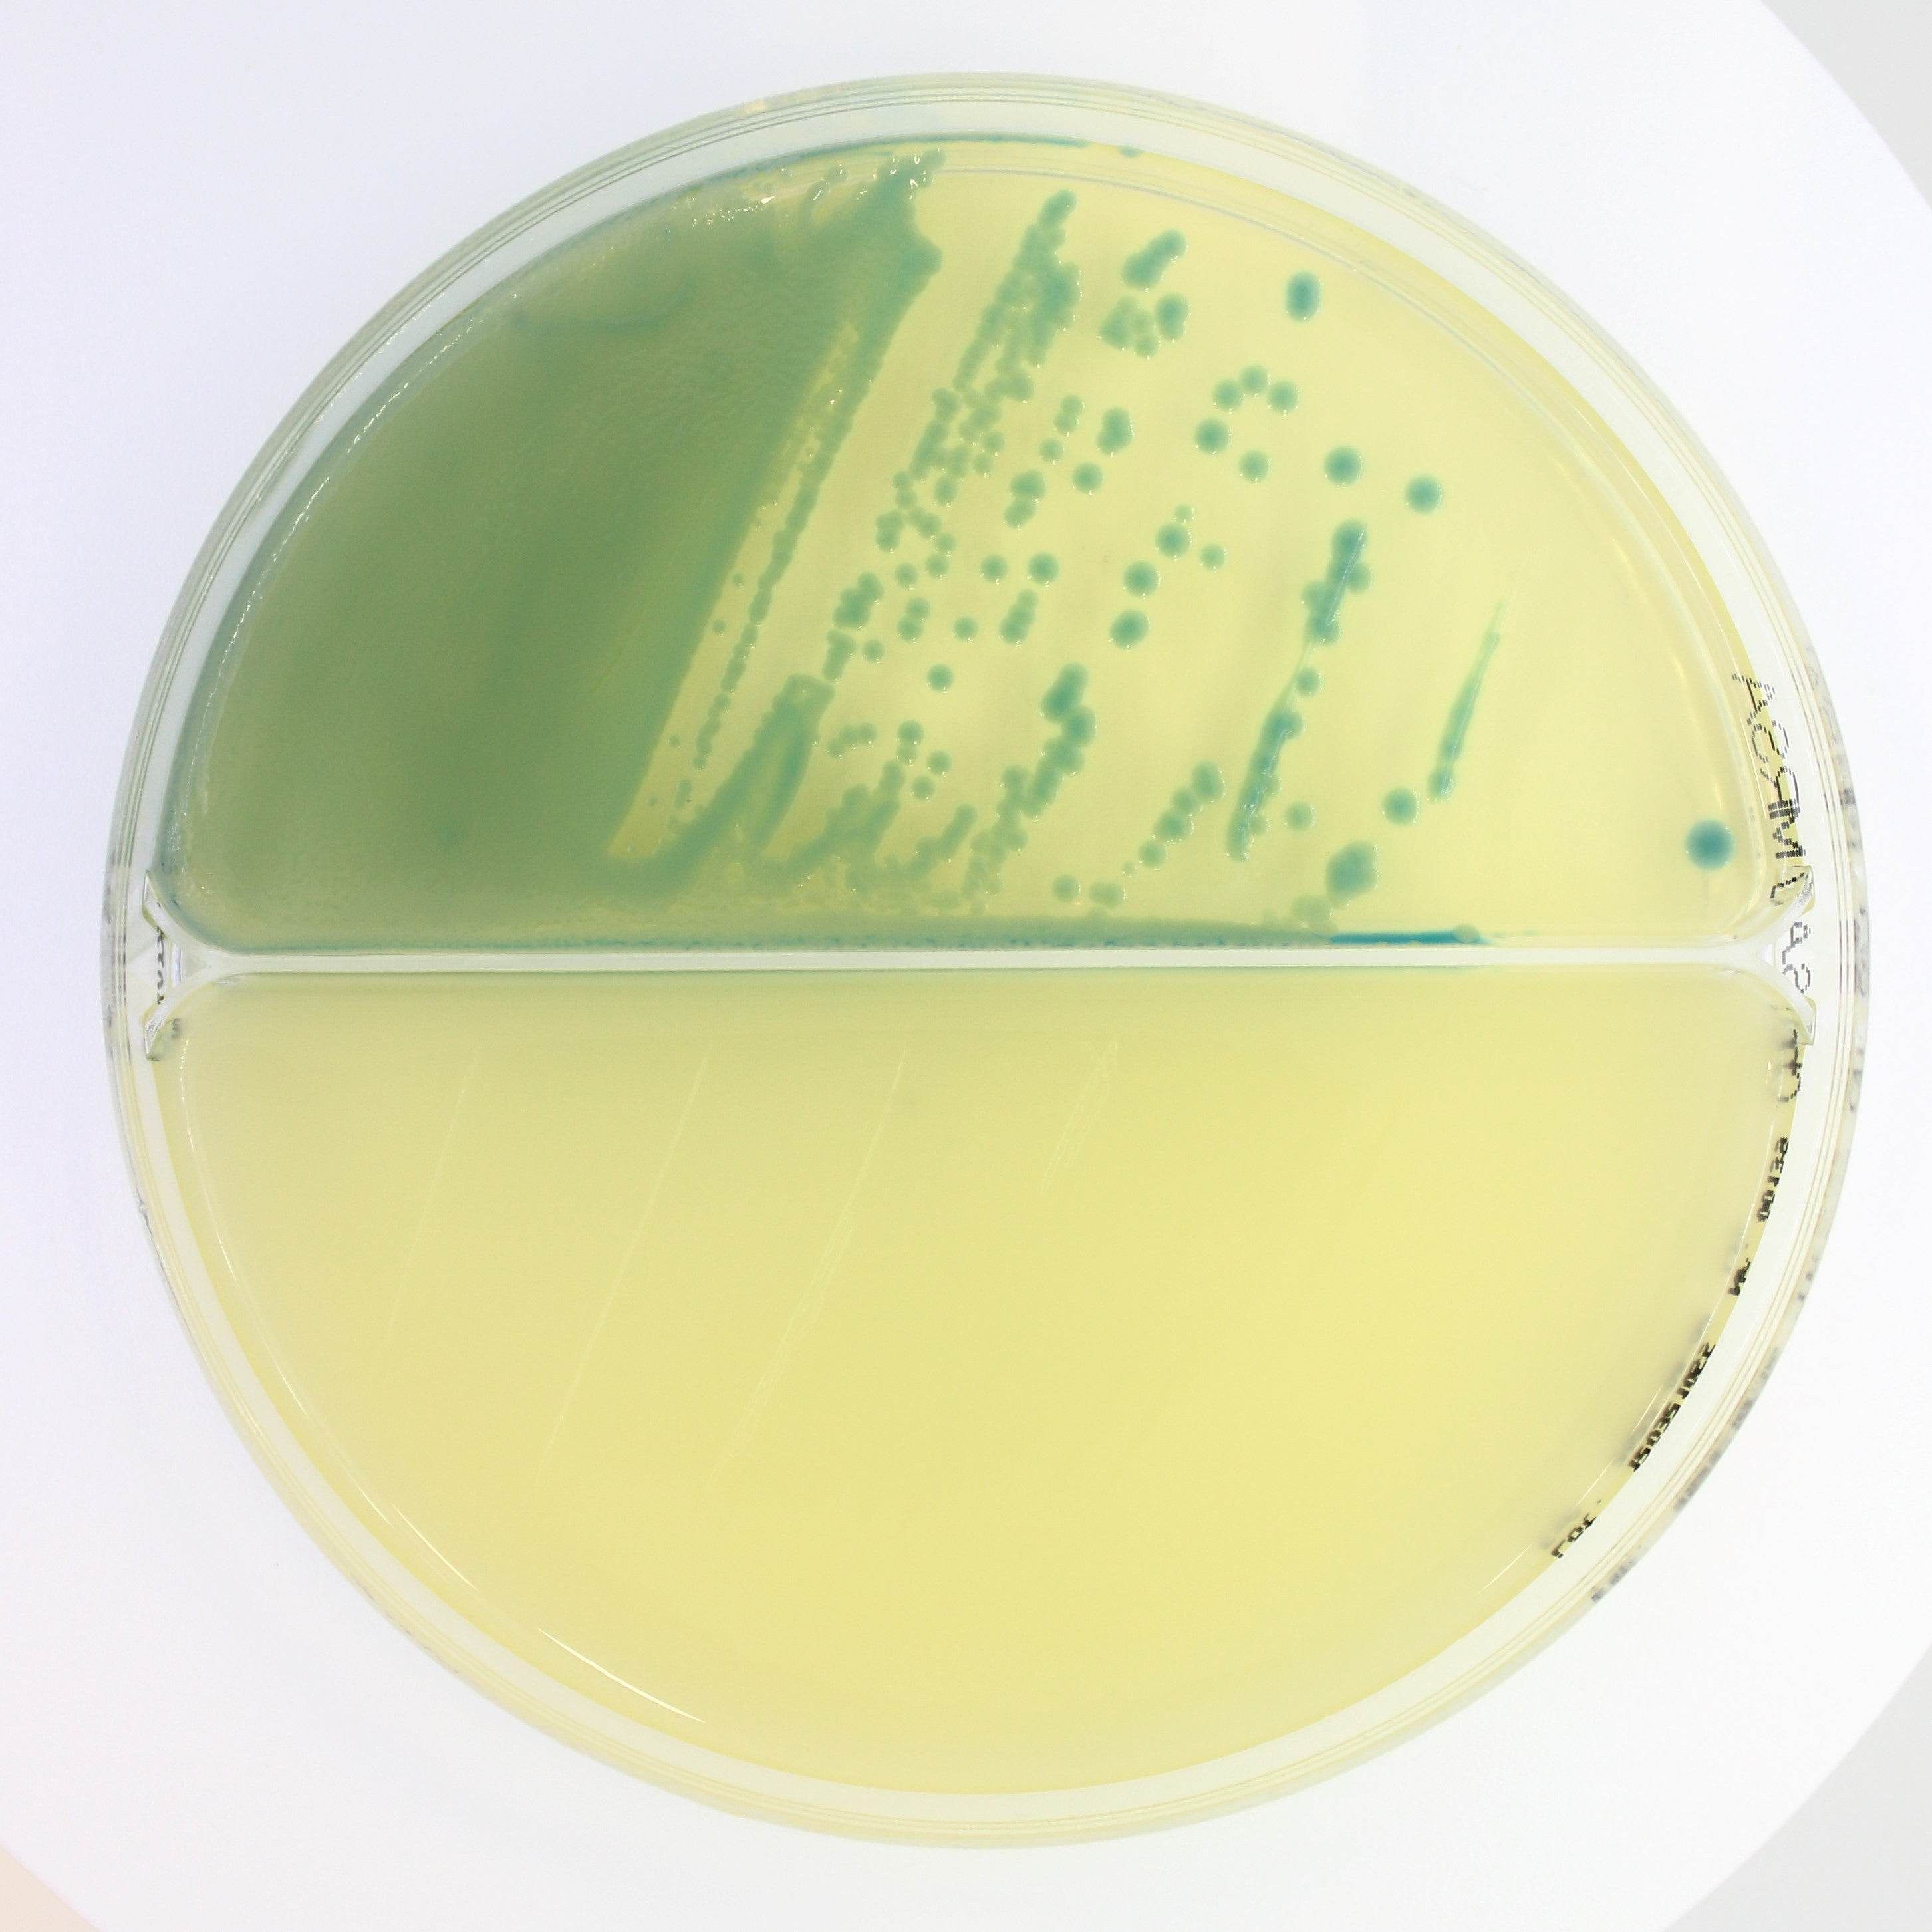
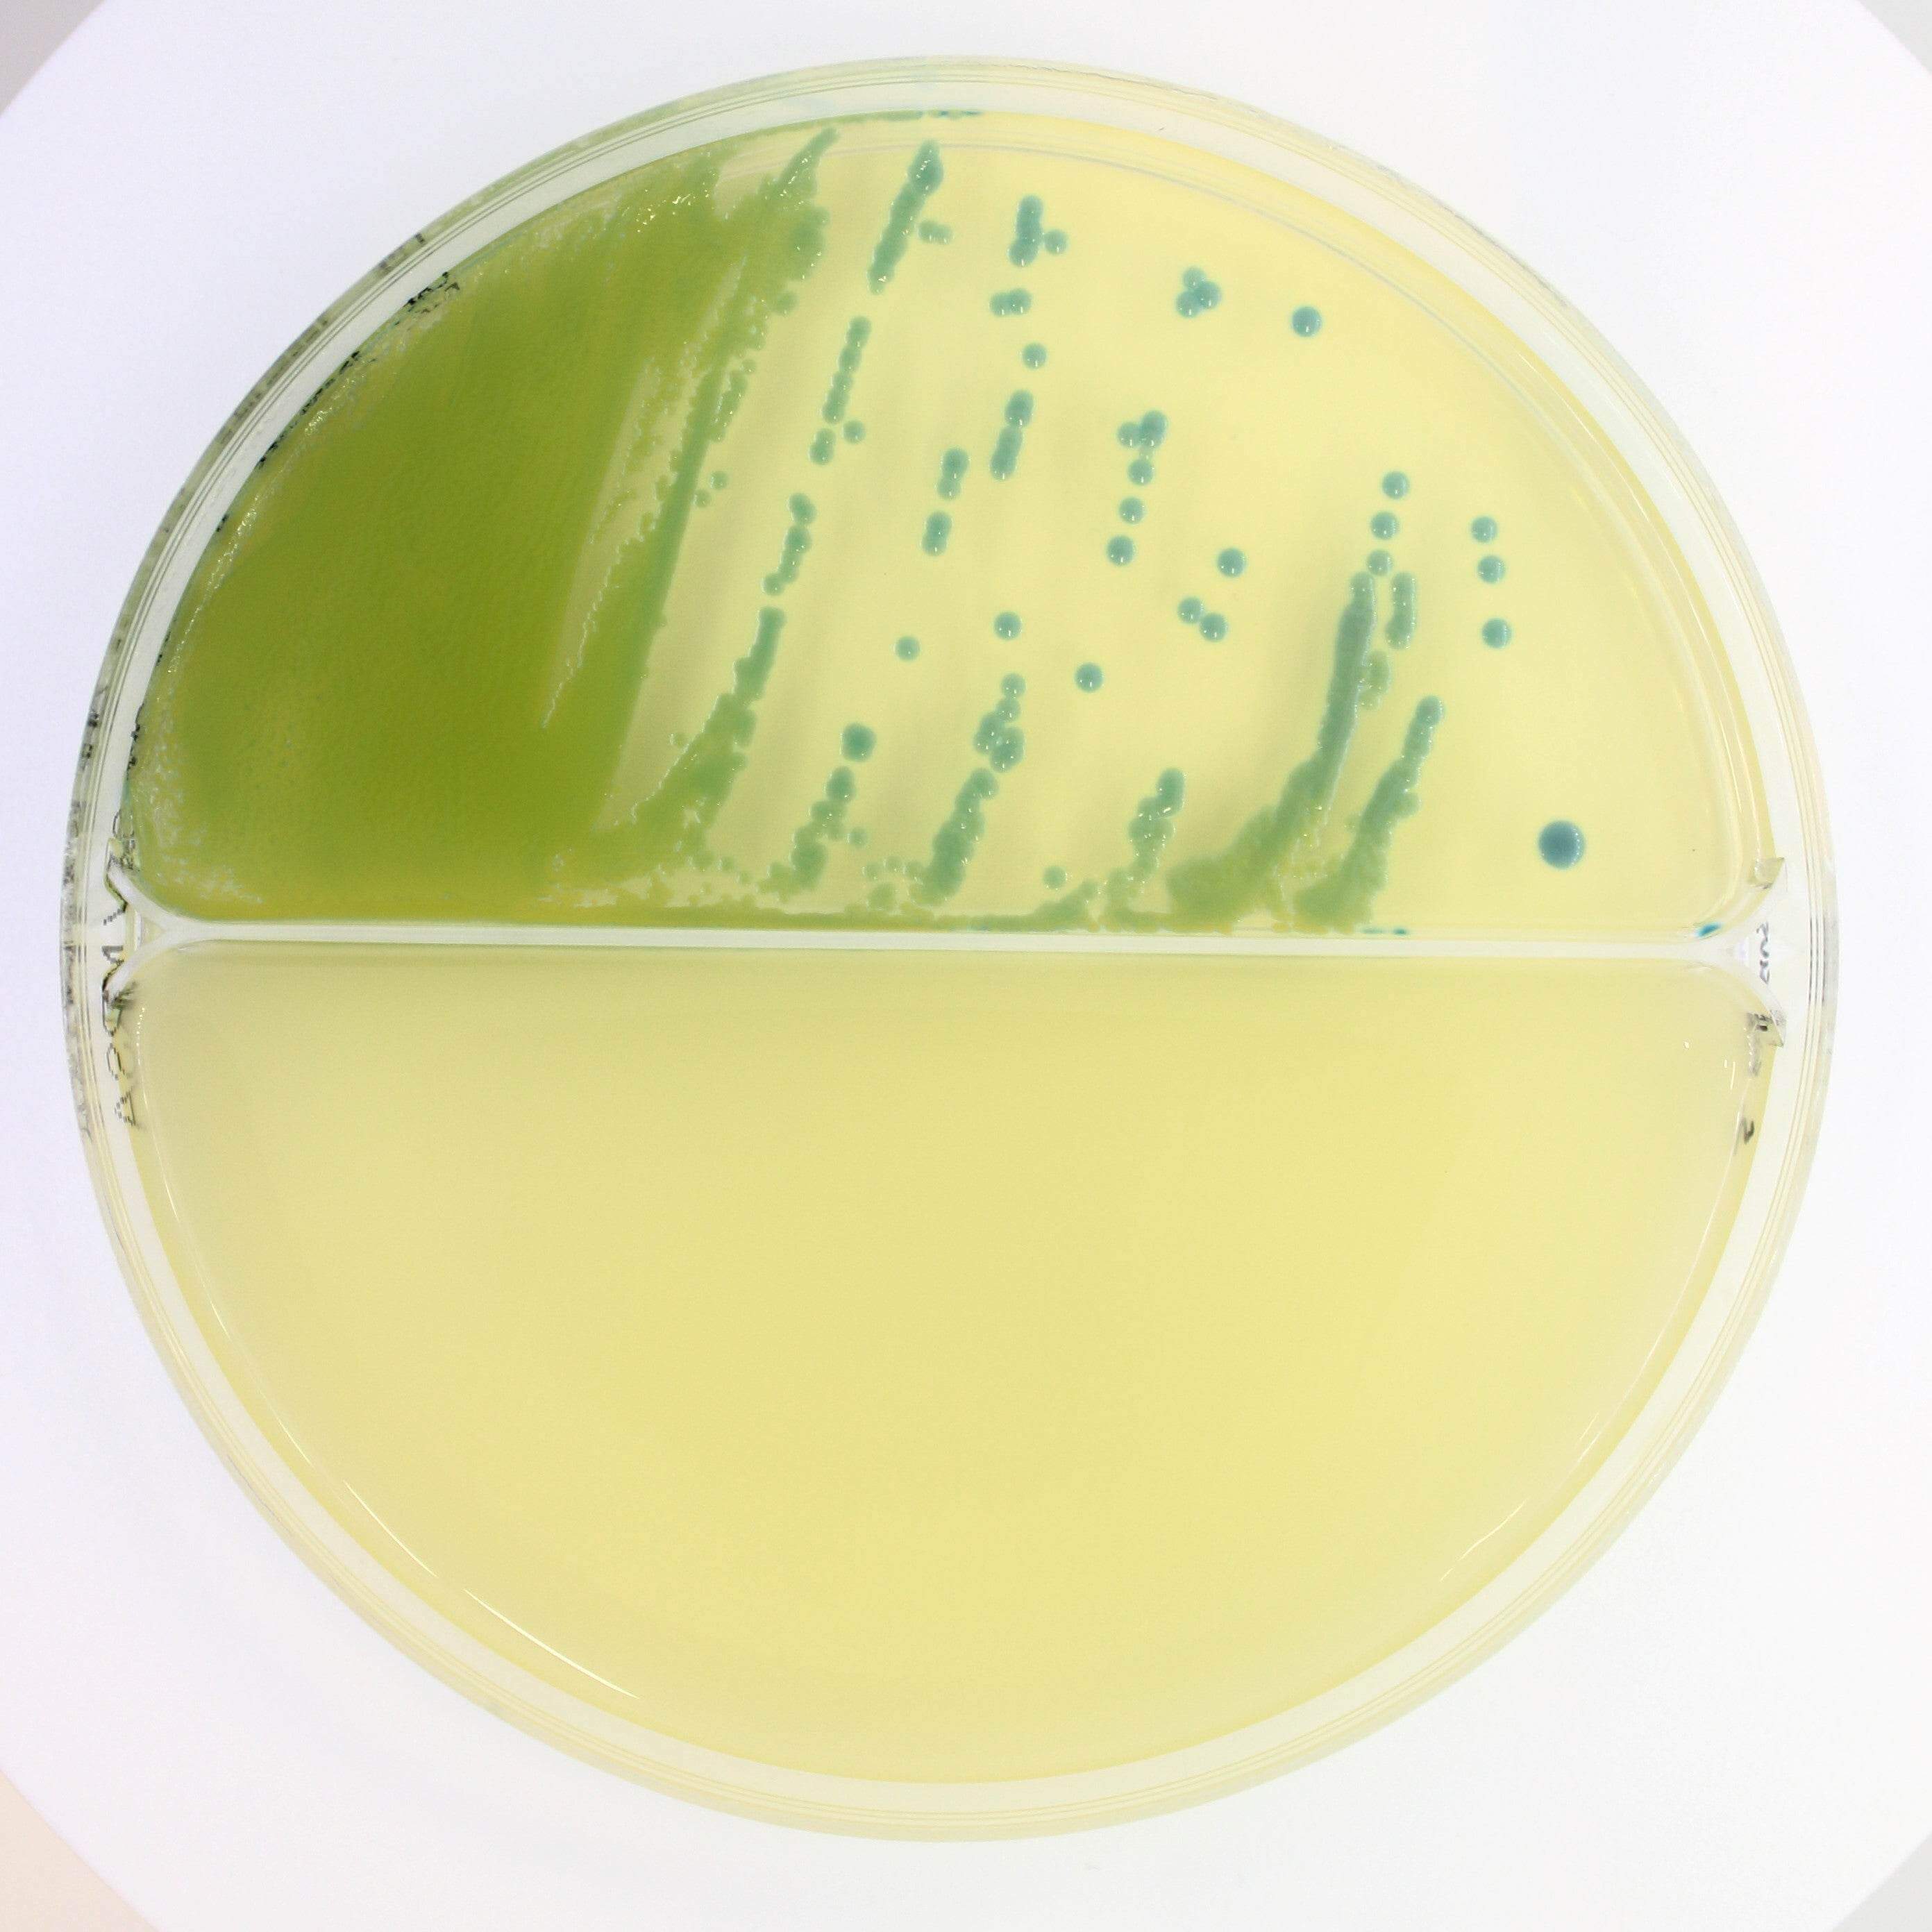
Chromatic STAPH AUREUS/ MRSA - Kormay Biomedicals store

Description
CHROMATIC STAPH AUREUS medium has a clear appearance and light amber colour, and is used for Staphylococcus aureus isolation.
CHROMATIC MRSA medium has an opaque and cloudy appearance and light beige colour, and is used for methicillin- resistant Staphylococcus aureus isolation.
Payment & Security
Your payment information is processed securely. We do not store credit card details nor have access to your credit card information.